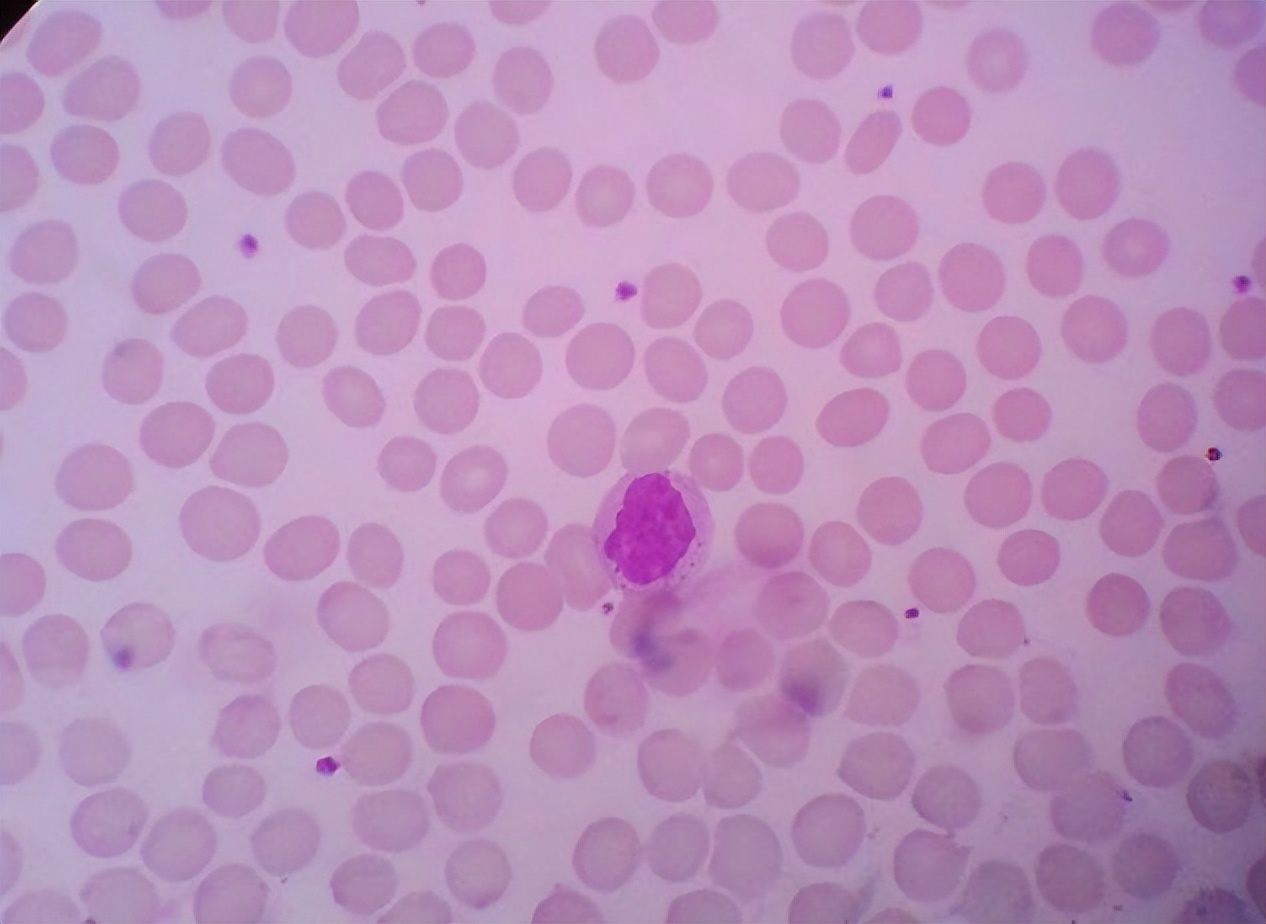
感染性发热血常规哪项指标升高,血常规检查的各项指标偏高

“人生七十古来稀”,在古代,七十岁的人甚是罕见,而如今,百岁老人也不足为奇,这离不开人们对健康生活的追求。
正因如此,越来越多的人开始重视体检,定期体检有利于及时掌握自己的健康状况,从而调整生活和工作节奏,那么,你能看懂体检报告吗?

此外,我们身体的状况分为:完全健康、亚健康、亚临床、临床,前三种情况都需健康管理,只有临床状态需要疾病管理。
因此,想要了解自身的健康状况就要定期体检,及时发现问题,早发现早治疗。
那么,血常规检查是最方便最快捷的血液检查方式,通过血液分析仪对全血中白细胞、红细胞、血红蛋白及血小板各方面检测。
血液是维持身体正常代谢功能的关键物质,它可以运输人体产生的激素和生物活性物质,清除组织和器官产生的代谢废物,调节身体功能,血常规检查结果可以反映人体的健康和疾病。

为什么去医院看病,先要抽血化验?
抽血检查是一个笼统的概念,我们常说的抽血检查包括的项目和内容太多,常见的比如有:血常规、肝肾功能、心肌酶、C-反应蛋白、血糖血脂、血淀粉酶等。
因此,我们需要先明白一个概念,去医院抽血,就是抽血化验,而通常所说的验血,在医学上属于实验诊断学。
它是应用物理、化学、生物、生化、免疫、遗传等技术和方法,对人体血液进行检验,以获取疾病原因、病理变化、器官功能状态等资料,协助疾病诊断、病情观察和疗效判断的学科,验血只是实验诊断学学科里面的一部分。
众所周知,由于血液是体内最活跃的成分,血液不断在全身循环,流经身体各个重要器官,渗透到各组织中,参与人体的新陈代谢。
所以血液是反映体内机能、健康状况最常用的和敏感的标本,因而临床上抽血检查几乎必不可少,抽血检查是辅助医生诊断疾病的重要手段。

血常规检查中,若这3个指标升高,不妨做进一步检查,建议了解
白细胞 指数增加
白细胞正常存在于血液和淋巴结当中,也是身体当中非常活跃的一种白细胞,同时白细胞也是人体与疾病作斗争的安全卫士。
当外界有细菌病毒入侵身体的时候,白细胞就会迅速变,身为保护机体健康的卫士,将细菌病毒阻挡在身体外面,避免身体生病。
正常情况下来说,白细胞的正常参考数值为(4.0~10.0)x 10^9/L,但如果发现白细胞数量升高,说明身体炎症比较高。
如果不能及时治疗,可能就会导致细菌病毒入侵越来越多,甚至越来越多,甚至诱发癌变,导致全身器官系统功能性瓦解,也希望大家提高警惕。

血红蛋白指数增加
中国成年男性血红蛋白正常值为120g/l至160g/l,女性为110g/l至150g/l。
高血红蛋白意味着患者的血红蛋白略高于正常值的上限,不会对人体造成太大伤害,然而,患者必须注意它,并定期检查,看看它是否保持在高位或随时间逐渐增加。
如果血红蛋白水平逐渐升高或超过正常上限,将对人体造成极大危害,一般来说,过高的血红蛋白水平会导致血液非常黏稠,容易引起血管栓塞,如常见的脑梗死、肢体血栓形成等。

淋巴细胞数量升高
淋巴细胞占据人体血液总成分的近36%,是依靠内源性分泌和外源性补充来进行分合。淋巴细胞的异常可以分为两种类型,一种是生理性的,一种是病理性的。
如果因为某些因素导致体内有炎症,那么淋巴细胞的数量就会比正常情况下有增高,在这种情况下,可以通过服用消炎药来将炎症缓解。
还有一点要注意的是,淋巴细胞的数量也不能太少,因为太少的话就要警惕白血病以及其他疾病,需要做进一步检查。
阅读延伸:血常规可以检查出癌症吗?
一般情况下,血常规是不可以检查出癌症的。如肺癌、胃癌等,具体分析如下:
通常,血常规主要检查的是血液中的白细胞、红细胞、血小板等指标,如白细胞反映的是机体的抗感染能力,通过白细胞的数量,可以推测机体是否患有白血病,通过红细胞的数量可以推测机体是否存在贫血的情况。
因此,血常规通常不可以检查出肺癌、胃癌、宫颈癌等癌症。
如果患者想要检查是否患有癌症,如肺癌、胃癌、宫颈癌等,需要去医院就诊,并在医生的指导下做相关检查来确诊。
如B超检查、磁共振成像检查等,不能盲目进行治疗,以免给身体带来不良的影响。

结语:你了解了吗?